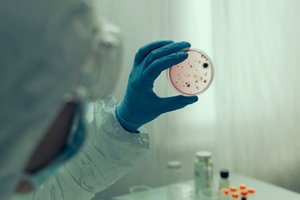
Kinijoje aptikta nauja infekcija

Ši grybelinė liga – miltligė – kurią sukelia dvi skirtingos grybų atmainos, pasireiškia baltu apnašų pavidalu ant augalų. Ji mažina derlių ir didina priklausomybę nuo fungicidų.
Komanda nustatė, kad per pastaruosius 12 metų miltligė išplito visame pasaulyje.
Viena grybų atmaina pateko į Kiniją – didžiausią pasaulyje šilauogių augintoją, tap pat į Meksiką ir Kaliforniją, o kita atmaina – į Maroką, Peru ir Portugaliją.
Susiję straipsniai
Šiaurės Karolinos universiteto (JAV) profesoriaus asistentas Michaelis Bradshawas sakė, kad tai „sunkiai kontroliuojamas organizmas“ – tai reiškia, kad, jei grybeliu užsikrėtę augalai yra transportuojami į įvairias pasaulio šalis, tikėtina, jog grybelis gali tose šalyse paplisti.
Miltligė padengia augalus nešiotojus apnašomis ir veikia beveik parazitiškai. Pasisavindamas augalų maistines medžiagas ir sulėtindamas fotosintezės procesą, grybelis auga kartu palaikydamas nešiotojo gyvybę.
Su naujuoju atradimu atsiranda viltis, kad bus galima lengviau nustatyti ir taip sulėtinti bei patogiau valdyti ligos plitimą.
Kadangi grybą, sukeliantį šialuogių miltligę, gali būti sunku identifikuoti, Šiaurės Karolinos universiteto mokslininkai sukūrė duomenų bazę, kuria gali naudotis tiek mokslininkai, tiek ūkininkai, norėdami pranešti ir peržiūrėti anksčiau pateiktus duomenis apie šią grybelinę ligą.
Ši platforma leidžia augintojams įvesti savo duomenis ir sužinoti, kokia konkreti padermė yra paplitusi jų ūkiuose, – sakė M. Bradshawas. – Tai svarbu, nes supratimas apie genetiką gali įspėti ūkininkus apie tai, kokia grybelio atmaina pas juos yra, ar ji atspari fungicidams, kaip liga plinta ir koks yra konkrečių atmainų virulentiškumas.“
Šis grybelis daugiausia aptinkamas šilauogėse, tačiau nustatyta, kad jis gali užkrėsti ir kviečius, apynius, vynuoges ir braškes, rašo „Daily Mail“.